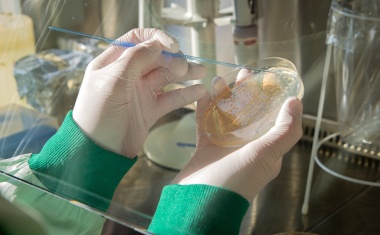
Photo
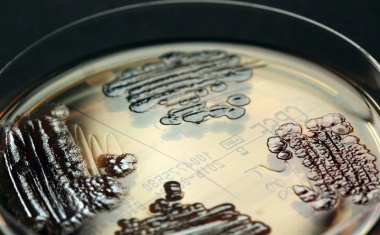
Photo
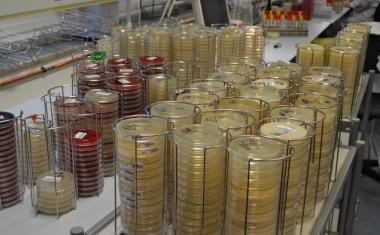
Photo

Exzellente Händehygiene: Universitätsklinikum Halle erhält Goldzertifizierung
Das Universitätsklinikum Halle (Saale) wurde mit dem Goldzertifikat der bundesweiten „Aktion Saubere Hände“ ausgezeichnet.

Das Universitätsklinikum Halle (Saale) wurde mit dem Goldzertifikat der bundesweiten „Aktion Saubere Hände“ ausgezeichnet.

Das Jahr 2024 soll Mitarbeitenden der Hochschulmedizin Dresden einen fokussierten Blick auf die Patientensicherheit geben.

Laut einer von Hartmann in Auftrag gegebenen Umfrage sieht die überwiegende Mehrheit der Befragten ihre Kliniken kurz- und langfristig durch nosokomiale Infektionen bedroht.

Krankenhausinfektionen sind ein ernstes Problem. Gefährliche Keime können auf verschiedenen Oberflächen in medizinischen Einrichtungen überdauern und die Gesundheit von Patienten gefährden.

Deutsch-amerikanisches Forschungsteam wirft Licht auf die Entstehung pathogener Acinetobacter-Arten.

Eingekapseltes Peptid blockiert Kommunikation und Virulenz resistenter Staphylokokken.

Ein Forschungsprojekt, das die Hochschule Hamm-Lippstadt jetzt gemeinsam mit der Firma ION-GAS aus Dortmund und der Universität Witten/Herdecke / Helios Universitätsklinikum Wuppertal startet, hat das Ziel, nosokomiale Atemwegsinfektionen frühzeitig zu erkennen.